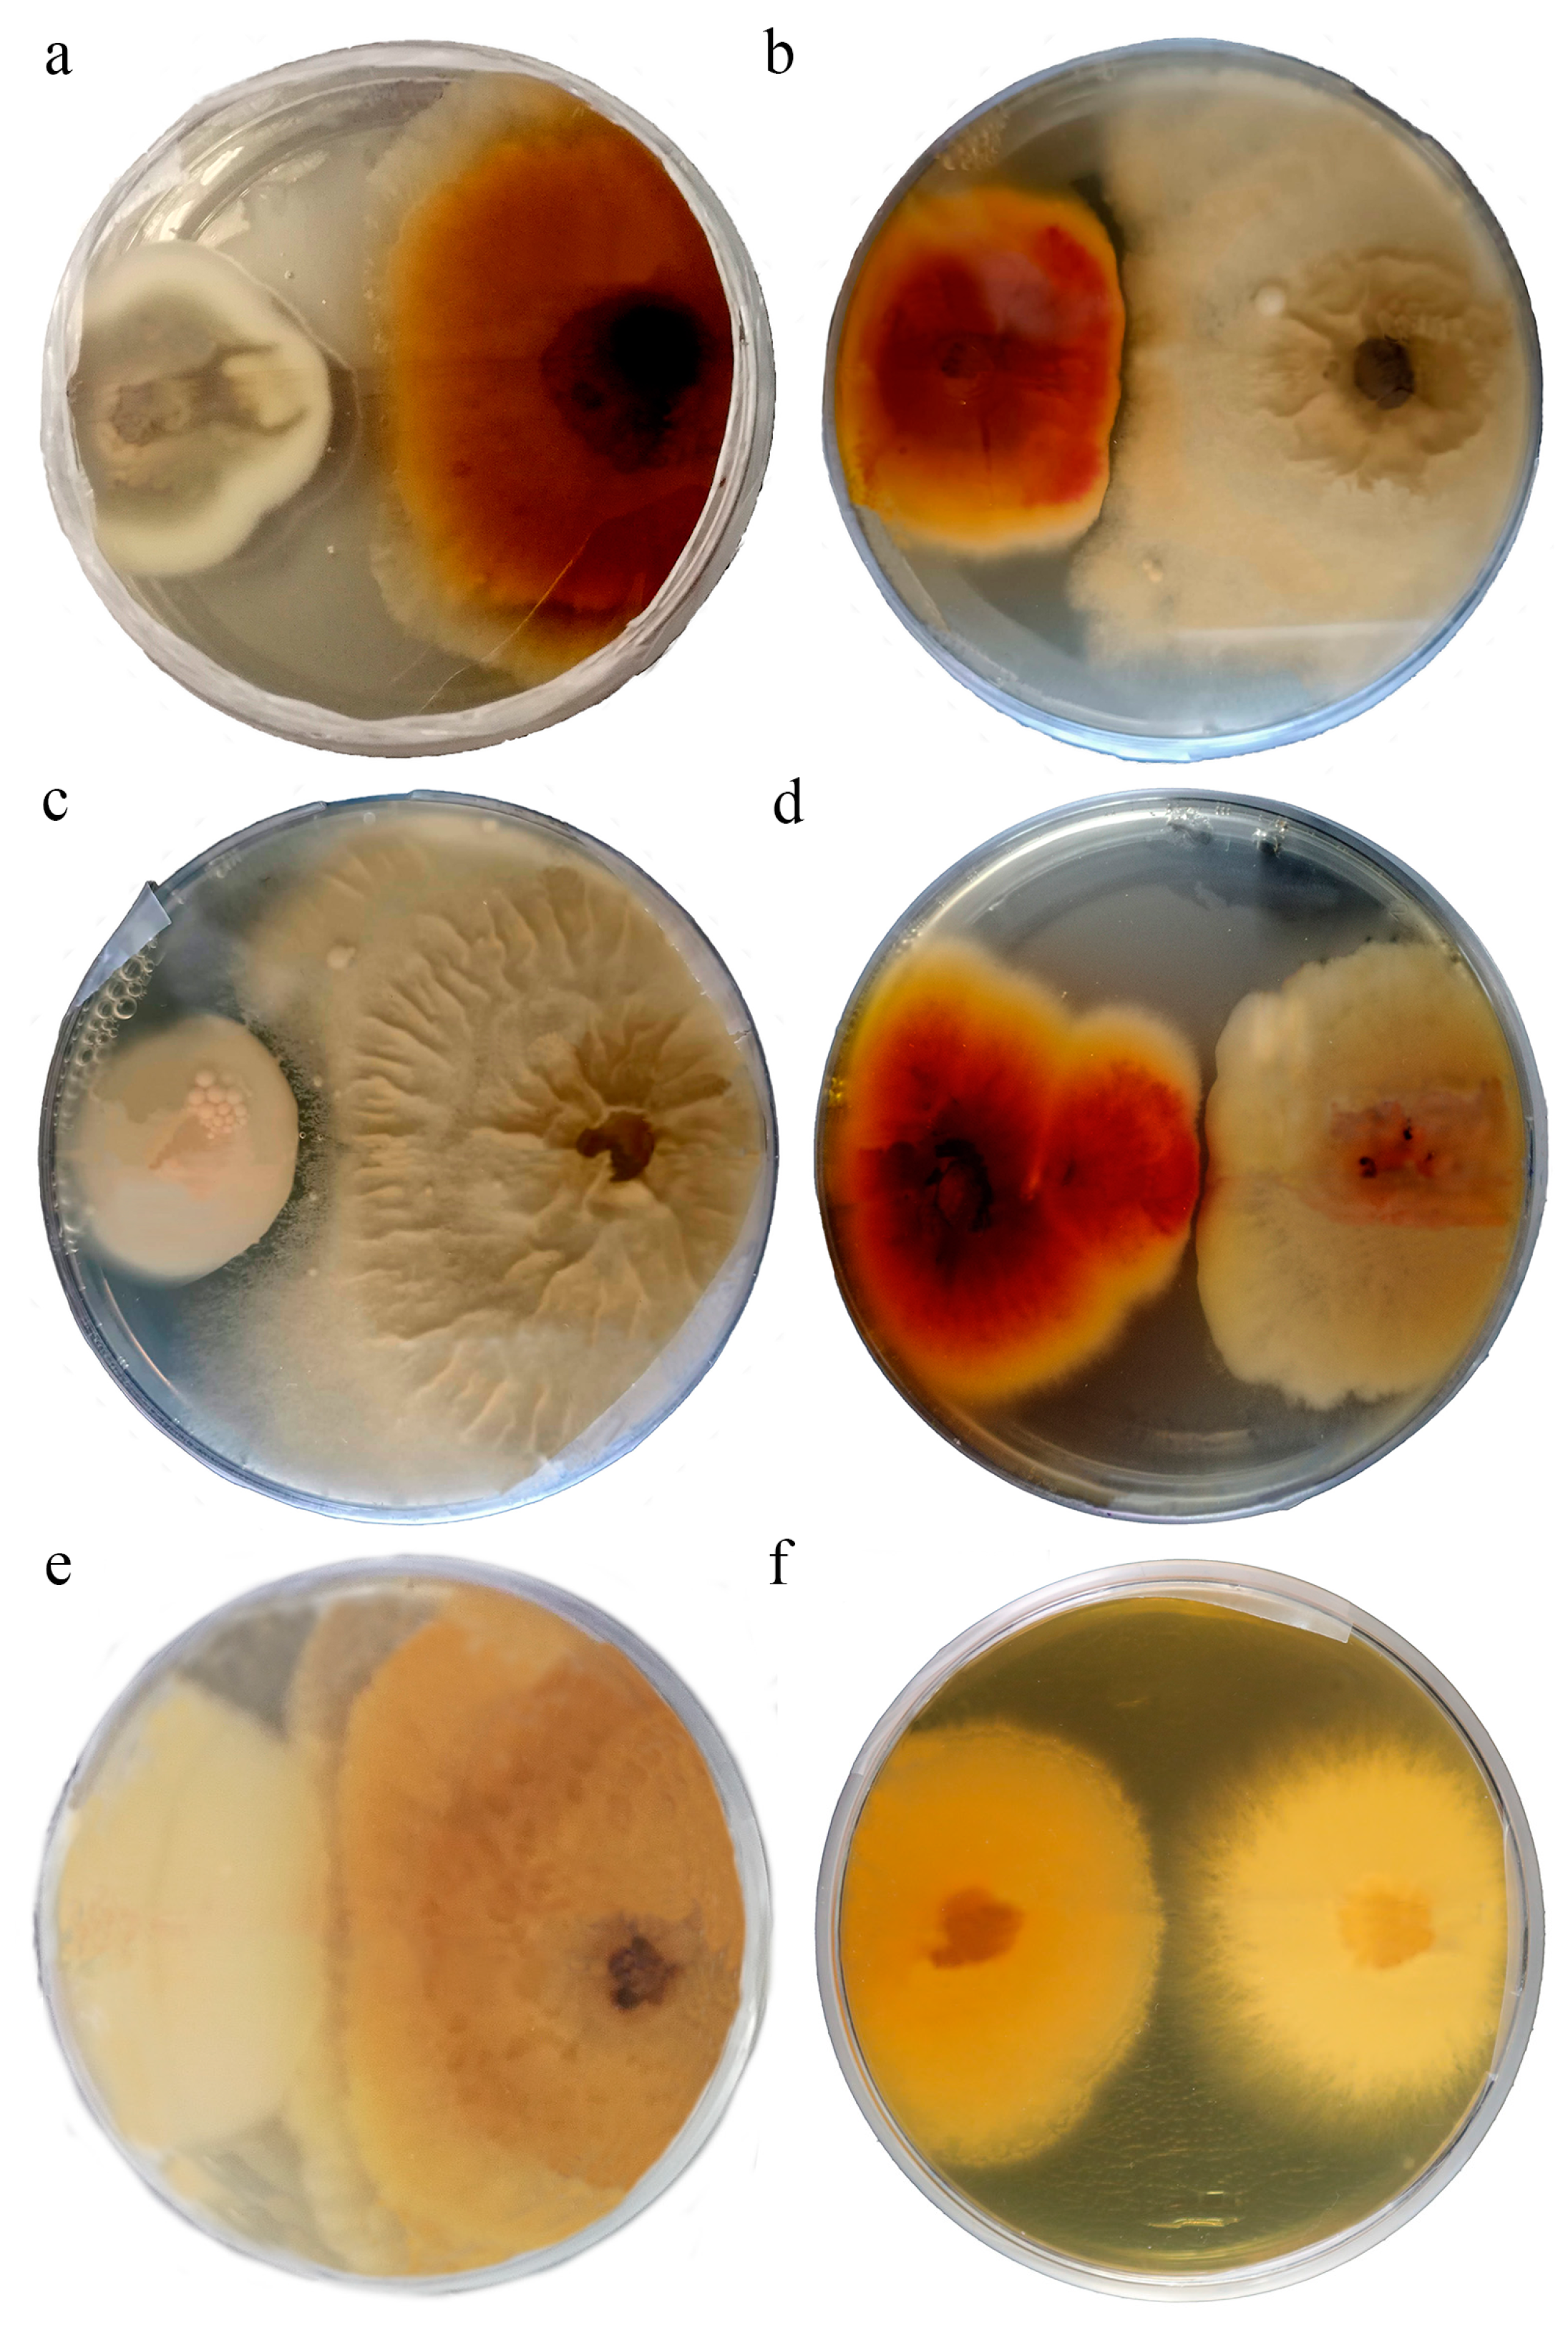
Diversity 17 00094 g002

Exploring Endophytic Fungi from Humulus lupulus L. for Biocontrol of Phytopathogenic Fungi
Abstract
1. Introduction
2. Materials and Methods
2.1. Biological Material and Study Sites
2.2. Isolation of Fungi and Molecular Identification
2.3. OTUs Molecular Identification and Phylogenetic Analysis
2.4. Diversity Analyses
2.5. Antifungal Activity of Isolated Endophytic Fungi
2.5.1. Dual-Culture Assays
2.5.2. Agar Diffusion Method
3. Results
3.1. Isolation and Identification of Hop Endophytic Fungi
3.2. Characterization and Distribution of Endophytic Fungi in the Different Tissues and Sampling Sites
3.3. Interaction Tests
4. Discussion
4.1. Diversity of Hop Endophytic Fungi
4.2. Antifungal Activities of the Isolated Strains
5. Conclusions
Supplementary Materials
Author Contributions
Funding
Institutional Review Board Statement
Data Availability Statement
Conflicts of Interest
References
- Zanoli, M.; Zavatti, M. Pharmacognostic and pharmacological profile of Humulus lupulus L. J. Ethnopharmacol. 2008, 116, 383–396. [Google Scholar] [CrossRef]
- Lamy, V.; Roussi, S.; Chaabi, M.; Gossé, F.; Schall, N.; Lobstein, A.; Raul, F. Chemopreventive effects of lupulone, a hop b-acid, on human colon cancer-derived metastatic SW620 cells and in a rat model of colon carcinogenesis. Carcinogenesis 2007, 28, 1575–1581. [Google Scholar] [CrossRef]
- Liu, M.; Hansen, P.E.; Wang, G.; Qiu, L.; Dong, J.; Yin, H.; Qian, Z.; Yang, M.; Miao, J. Pharmacological Profile of Xanthohumol, a Prenylated Flavonoid from Hops (Humulus lupulus). Molecules 2015, 20, 754–779. [Google Scholar] [CrossRef]
- Van Cleemput, M.; Cattoor, K.; De Bosscher, K.; Haegeman, G.; De Keukeleire, D.; Heyerick, A. Hop (Humulus lupulus)-derived bitter acids as multipotent bioactive compounds. J. Nat. Prod. 2009, 72, 1220–1230. [Google Scholar] [CrossRef]
- Licciardo, F.; Carbone, K.; Ievoli, C.; Manzo, A.; Tarangioli, S. Outlook Economico-Statistico del Comparto Luppolo. 2021. Available online: https://www.reterurale.it/flex/cm/pages/ServeBLOB.php/L/IT/IDPagina/22822 (accessed on 25 October 2024).
- Gargani, E.; Ferretti, L.; Faggioli, F.; Haegi, A.; Luigi, M.; Landi, S.; Simoni, S.; Benvenuti, C.; Guidi, S.; Simoncini, S.; et al. A survey on pests and diseases of Italian hop crops. Italus Hortus 2018, 24, 1–17. [Google Scholar] [CrossRef]
- Rossini, F.; Virga, G.; Loreti, P.; Iacuzzi, N.; Ruggeri, R.; Provenzano, M.E. Hops (Humulus lupulus L.) as a Novel Multipurpose Crop for the Mediterranean Region of Europe: Challenges and Opportunities of Their Cultivation. Agriculture 2021, 11, 484. [Google Scholar] [CrossRef]
- Porteous-Álvarez, A.J.; Maldonado-González, M.M.; Mayo-Prieto, S.; Lorenzana, A.; Paniagua-García, A.I.; Casquero, P.A. Green Strategies of Powdery Mildew Control in Hop: From Organic Products to Nanoscale Carriers. J. Fungi 2021, 7, 490. [Google Scholar] [CrossRef] [PubMed]
- Carroll, G.C. The biology of endophytism in plants. In Microbiology of the Phyllosphere; Fokkema, N.J., van den Heuvel, J., Eds.; Cambridge University Press: Cambridge, UK, 1986; pp. 205–222. [Google Scholar]
- Baron, N.C.; Rigobelo, E.C. Endophytic fungi: A tool for plant growth promotion and sustainable agriculture. Mycology 2022, 13, 39–55. [Google Scholar] [CrossRef] [PubMed]
- Deka, D.; Tayung, K.; Jha, D.K. Harnessing Fungal Endophytes for Plant and Human Health. In Endophytes: Biology and Biotechnology; Maheshwari, D.K., Ed.; Springer: Cham, Switzerland, 2017; Volume 1, pp. 59–98. [Google Scholar]
- Fontana, D.C.; de Paula, S.; Torres, A.G.; de Souza, V.H.M.; Pascholati, S.F.; Schmidt, D.; Dourado Neto, D. Endophytic Fungi: Biological Control and Induced Resistance to Phytopathogens and Abiotic Stresses. Pathogens 2021, 10, 570. [Google Scholar] [CrossRef]
- De Silva, N.I.; Brooks, I.; Lumyong, S.; Hyde, K.D. Use of endophytes as biocontrol agents. Fungal Biol. Rev. 2019, 33, 133–148. [Google Scholar] [CrossRef]
- Porteous-Álvarez, A.J.; Fernández-Marcos, A.; Ramírez-Lozano, D.; Mayo-Prieto, S.; Cardoza, R.E.; Gutiérrez, S.; Casquero, P.A. Native Trichoderma Isolates from Soil and Rootstock to Fusarium spp. Control and Growth Promotion of Humulus lupulus L. Plantlets. Agriculture 2023, 13, 720. [Google Scholar] [CrossRef]
- Belfiori, B.; Rubini, A.; Riccioni, C. Diversity of endophytic and pathogenic fungi of saffron (Crocus sativus) plants from cultivation sites in Italy. Diversity 2021, 13, 535. [Google Scholar] [CrossRef]
- Arnold, A.E.; Lutzoni, F. Diversity and Host Range of Foliar Fungal Endophytes: Are Tropical Leaves Biodiversity Hotspots? Ecology 2007, 88, 541–549. [Google Scholar] [CrossRef]
- Gardes, M.; Bruns, T.D. ITS primers with enhanced specificity for basidiomycetes application to the identification of mycorrhizae and rusts. Mol. Ecol. 1993, 2, 113–118. [Google Scholar] [CrossRef]
- White, T.J.; Bruns, T.; Lee, S.; Taylor, J. Amplification and direct sequencing of fungal ribosomal RNA genes for phylogenetics. In PCR Protocols. A Guide to Methods and Applications; Innis, M.A., Gelfand, D.H., Sninsky, J.J., White, T.J., Eds.; Academic Press: San Diego, CA, USA, 1990; pp. 315–322. [Google Scholar]
- Rubini, A.; Paolocci, F.; Granetti, B.; Arcioni, S. Single Step Molecular Characterization of Morphologically Similar Black Truffle Species. FEMS Microbiol. Lett. 1998, 164, 7–12. [Google Scholar] [CrossRef]
- Altschul, S.F.; Gish, W.; Miller, W.; Myers, E.W.; Lipman, D.J. Basic Local Alignment Search Tool. J. Mol. Biol. 1990, 215, 403–410. [Google Scholar] [CrossRef]
- Huang, Y.; Niu, B.; Gao, Y.; Fu, L.; Li, W. CD-HIT Suite: A Web Server for Clustering and Comparing Biological Sequences. Bioinformatics 2010, 26, 680–682. [Google Scholar] [CrossRef]
- Põlme, S.; Abarenkov, K.; Henrik Nilsson, R.; Lindahl, B.D.; Clemmensen, K.E.; Kauserud, H.; Nguyen, N.; Kjøller, R.; Bates, S.T.; Baldrian, P.; et al. FungalTraits: A user-friendly traits database of fungi and fungus-like stramenopiles. Fungal Divers. 2020, 105, 1–16. [Google Scholar] [CrossRef]
- Katoh, K.; Standley, D.M. MAFFT multiple sequence alignment software version 7: Improvements in performance and usability. Mol. Biol. Evol. 2013, 30, 772–780. [Google Scholar] [CrossRef]
- Stamatakis, A. RAxML Version 8: A Tool for Phylogenetic Analysis and Post-Analysis of Large Phylogenies. Bioinformatics 2014, 30, 1312–1313. [Google Scholar] [CrossRef]
- Rivera-Orduña, F.N.; Suarez-Sanchez, R.A.; Flores-Bustamante, Z.R.; Gracida-Rodriguez, J.N.; Flores-Cotera, L.B. Diversity of Endophytic Fungi of Taxus Globosa (Mexican yew). Fungal Divers. 2011, 47, 65–74. [Google Scholar] [CrossRef]
- Hajieghrari, B.; Torabi-Giglou, M.; Mohammadi, M.R.; Davari, M. Biological potential of some Iranian Trichoderma isolates in the control of soil borne plant pathogenic fungi. Afr. J. Biotechnol. 2008, 7, 967–972. [Google Scholar]
- Edington, L.V.; Khew, K.L.; Barron, G.I. Fungitoxic spectrum of benzimidazole compounds. Phytopathology 1971, 61, 42–44. [Google Scholar] [CrossRef]
- Ofek-Lalzar, M.; Gur, Y.; Ben-Moshe, S.; Sharon, O.; Kosman, E.; Mochli, E.; Sharon, A. Diversity of fungal endophytes in recent and ancient wheat ancestors Triticum dicoccoides and Aegilops sharonensis. FEMS Microbiol. Ecol. 2016, 92, 1–11. [Google Scholar] [CrossRef]
- Mili, C.; Roy, S.; Tayung, K. Endophytic Fungi of Wild and Domesticated Crop Plants and Their Prospect for Applications in Sustainable Agriculture. In Endophytes; Patil, R.H., Maheshwari, V.L., Eds.; Springer: Singapore, 2021; pp. 21–35. [Google Scholar] [CrossRef]
- Kernaghan, G.; Mayerhofer, M.; Griffin, A. Fungal endophytes of wild and hybrid Vitis leaves and their potential for vineyard biocontrol. Can. J. Microbiol. 2017, 63, 583–595. [Google Scholar] [CrossRef]
- Murphy, B.R.; Doohan, F.M.; Hodkinson, T.R. From concept to commerce: Developing a successful fungal endophyte inoculant for agricultural crops. J. Fungi 2018, 4, 24. [Google Scholar] [CrossRef]
- Riccioni, C.; Belfiori, B.; Sileoni, V.; Marconi, O.; Perretti, G.; Bellucci, M.; Rubini, A. High genetic and chemical diversity of wild hop populations from Central Italy with signals of a genetic structure influenced by both sexual and asexual reproduction. Plant Sci. 2021, 304, 110794. [Google Scholar] [CrossRef]
- Baturo-Ciesniewska, A.; Pusz, W.; Patejuk, K. Problems, limitations, and challenges in species identifcation of Ascomycota members on the basis of ITS regions. Acta Mycol. 2020, 55, 1–18. [Google Scholar] [CrossRef]
- Trivedi, P.; Leach, J.E.; Tringe, S.G.; Sa, T.; Singh, B.K. Plant–microbiome interactions: From community assembly to plant health. Nat. Rev. Microbiol. 2020, 18, 607–621. [Google Scholar] [CrossRef]
- Kusari, P.; Kusari, S.; Spiteller, M.; Kayser, O. Endophytic fungi harbored in Cannabis sativa L.: Diversity and potential as biocontrol agents against host plant-specific phytopathogens. Fungal Divers. 2013, 60, 137–151. [Google Scholar] [CrossRef]
- Rashmi, M.; Kushveer, J.S.; Sarma, V.V. A worldwide list of endophytic fungi with notes on ecology and diversity. Mycosphere 2019, 10, 798–1079. [Google Scholar] [CrossRef]
- Shipunov, A.; Newcombe, G.; Raghavendra, A.K.; Anderson, C.L. Hidden diversity of endophytic fungi in an invasive plant. Am. J. Bot. 2008, 95, 1096–1108. [Google Scholar] [CrossRef] [PubMed]
- Khalmuratova, I.; Choi, D.H.; Woo, J.R.; Jeong, M.J.; Oh, Y.; Kim, Y.G.; Kim, J.G. Diversity and plant growth-promoting effects of fungal endophytes isolated from salt-tolerant plants. J. Microbiol. Biotechnol. 2020, 30, 1680. [Google Scholar] [CrossRef] [PubMed]
- Khan, A.R.; Ullah, I.; Waqas, M.; Shahzad, R.; Hong, S.J.; Park, G.S.; Jung, B.K.; Lee, I.J.; Shin, J.H. Plant growth-promoting potential of endophytic fungi isolated from Solanum nigrum leaves. World J. Microbiol. Biotechnol. 2015, 31, 1461–1466. [Google Scholar] [CrossRef]
- Teale, W.D.; Paponov, I.A.; Palme, K. Auxin in action: Signalling, transport and the control of plant growth and development. Nat. Rev. Mol. Cell Biol. 2006, 7, 847–859. [Google Scholar] [CrossRef]
- Fatima, N.; Ismail, T.; Muhammad, S.A.; Jadoon, M.; Ahmed, S.; Azhar, S.; Mumtaz, A. Epicoccum sp., an emerging source of unique bioactive metabolites. Acta Pol. Pharm. 2016, 73, 13–21. [Google Scholar]
- Braga, R.M.; Padilla, G.; Araújo, W.L. The biotechnological potential of Epicoccum spp.: Diversity of secondary metabolites. Crit. Rev. Microbiol. 2018, 44, 759–778. [Google Scholar] [CrossRef]
- Bagy, H.M.K.; Hassan, E.A.; Nafady, N.A.; Dawood, M.F. Efficacy of arbuscular mycorrhizal fungi and endophytic strain Epicoccum nigrum ASU11 as biocontrol agents against blackleg disease of potato caused by bacterial strain Pectobacterium carotovora subsp. atrosepticum PHY7. Biol. Control 2019, 134, 103–113. [Google Scholar] [CrossRef]
- Taguiam, J.D.; Evallo, E.; Balendres, M.A. Epicoccum species: Ubiquitous plant pathogens and effective biological control agents. Eur. J. Plant Pathol. 2021, 159, 713–725. [Google Scholar] [CrossRef]
- Úrbez-Torres, J.R.; Peduto, F.; Gubler, W.D. First report of Ilyonectria macrodidyma causing root rot of olive trees (Olea europaea) in California. Plant Dis. 2012, 96, 1378. [Google Scholar] [CrossRef]
- Dos Santos, R.F.; Blume, E.; Muniz, M.F.B.; Heckler, L.I.; Finger, G.; Maciel, C.G.; Garrido, L.D.R. First report of Ilyonectria macrodidyma associated with black foot disease of grapevine in Brazil. Plant Dis. 2014, 98, 156. [Google Scholar] [CrossRef] [PubMed]
- Radić, T.; Likar, M.; Hančević, K.; Regvar, M.; Čarija, M.; Zdunić, G. Root-associated community composition and co-occurrence patterns of fungi in wild grapevine. Fungal Ecol. 2021, 50, 101034. [Google Scholar] [CrossRef]
- Schulz, B.; Boyle, C. What Are Endophytes? In Microbial Root Endophytes; Schulz, B.J.E., Boyle, C.J.C., Sieber, T.N., Eds.; Springer: Berlin, Germany, 2006; pp. 1–13. [Google Scholar]
- Schulz, B.; Römmert, A.K.; Dammann, U.; Aust, H.J.; Strack, D. The Endophyte-Host Interaction: A Balanced Antagonism? Mycol. Res. 1999, 103, 1275–1283. [Google Scholar] [CrossRef]
- Wilson, D. Endophyte: The Evolution of a Term, and Clarification of Its Use and Definition. Oikos 1995, 73, 274–276. [Google Scholar] [CrossRef]
- Wearn, J.A.; Sutton, B.C.; Morley, N.J.; Gange, A.C. Species and organ specificity of fungal endophytes in herbaceous grassland plants. J. Ecol. 2012, 100, 1085–1092. [Google Scholar] [CrossRef]
- Pétriacq, P.; Stassen, J.H.M.; Ton, J. Spore Density Determines Infection Strategy by the Plant Pathogenic Fungus Plectosphaerella cucumerina. Plant Physiol. 2016, 170, 2325–2339. [Google Scholar] [CrossRef]
- Girardi, N.; Sosa, A.L.; Loyola García, J.; Pellegrino, M.; Passone, M.A. Ecophysiological characteristics of the nematophagous fungus, Plectosphaerella plurivora, with biocontrol potential on Nacobbus aberrans sl in tomato. Eur. J. Plant Pathol. 2023, 167, 867–881. [Google Scholar] [CrossRef]
- Zhou, J.; Bi, S.; Chen, H.; Chen, T.; Yang, R.; Li, M.; Fu, Y.; Jia, A.Q. Anti-biofilm and antivirulence activities of metabolites from Plectosphaerella cucumerina against Pseudomonas aeruginosa. Front. Microbiol. 2017, 8, 769. [Google Scholar] [CrossRef]
- Prasongsuk, S.; Lotrakul, P.; Ali, I.; Bankeeree, W.; Punnapayak, H. The current status of Aureobasidium pullulans in biotechnology. Folia Microbiol. 2018, 63, 129–140. [Google Scholar] [CrossRef]
- Bozoudi, D.; Tsaltas, D. The multiple and versatile roles of Aureobasidium pullulans in the vitivinicultural sector. Fermentation 2018, 4, 85. [Google Scholar] [CrossRef]
- Azhari, A.; Supratman, U. The chemistry and pharmacology of fungal genus Periconia: A review. Sci. Pharm. 2021, 89, 34. [Google Scholar] [CrossRef]
- Manoch, L.; Dethoup, T. A potential use of Talaromyces species as biological agents against plant pathogenic fungi. Thai J. Agric. Sci. 2011, 44, 81–91. [Google Scholar]
- Wu, Z.; Xie, Z.; Wu, M.; Li, X.; Li, W.; Ding, W.; Li, C. New antimicrobial cyclopentenones from Nigrospora sphaerica ZMT05, a fungus derived from Oxya chinensis Thunber. J. Agric. Food Chem. 2018, 66, 5368–5372. [Google Scholar] [CrossRef] [PubMed]
- Yilmaz, N.; Visagie, C.M.; Houbraken, J.; Frisvad, J.C.; Samson, R.A. Polyphasic taxonomy of the genus Talaromyces. Stud. Mycol. 2014, 78, 175–341. [Google Scholar] [CrossRef]
- Lan, D.; Wu, B. Chemistry and bioactivities of secondary metabolites from the genus Talaromyces. Chem. Biodivers. 2020, 17, e2000229. [Google Scholar] [CrossRef]

| Sampling Site | Locality | Region | Latitude | Longitude | No. Isolates per Tissue | |||||
|---|---|---|---|---|---|---|---|---|---|---|
| Roots | Stems | Leaves | Cones | Male Flowers | Total | |||||
| 1 | Ponte San Giovanni | Umbria | 43.092056 | 12.461544 | 4 | 22 | 5 | 31 | ||
| 2 | Valfabbrica | Umbria | 43.327520 | 12.718487 | 12 | 11 | 23 | |||
| 3 | Città di Castello | Umbria | 43.457615 | 12.230473 | 10 | 6 | 16 | 23 | 7 | 62 |
| 4 | Belfiore | Umbria | 42.981651 | 12.734363 | 5 | 5 | 10 | 14 | 34 | |
| 5 | Nera River | Umbria | 42.734921 | 12.833146 | 4 | 19 | 23 | |||
| 6 | Piediluco | Umbria | 42.530727 | 12.733482 | 12 | 9 | 25 | 5 | 51 | |
| 7 | Orvieto | Umbria | 42.697959 | 12.211644 | 2 | 3 | 5 | |||
| 8 | Bolsena Lake | Lazio | 42.638573 | 11.889101 | 7 | 3 | 4 | 14 | ||
| 9 | Potenza River | Marche | 43.246611 | 13.219093 | 5 | 5 | ||||
| 10 | Penna San Giovanni | Marche | 43.049822 | 13.464626 | 14 | 14 | ||||
| Total no. isolates | 27 | 24 | 98 | 102 | 11 | 262 | ||||
| Isolates | Closest Match in GenBank | No. of Isolates | Pi | |||||||||||||
|---|---|---|---|---|---|---|---|---|---|---|---|---|---|---|---|---|
| OTU | Strain | Accession No. | Classification | Accession No. | Similarity (%) | Roots | Stems | Leaves | Cones | Male Flowers | Total | Roots | Stems | Leaves | Cones | Male Flowers |
| ASCOMYCOTA | ||||||||||||||||
| DOTHIDEOMYCETES | ||||||||||||||||
| Pleosporales | ||||||||||||||||
| 1 | E140 | OQ257068 | Alternaria sp. | AF347031 | 100 | 7 | 23 | 45 | 7 | 82 | 0.304 * | 0.235 * | 0.447 * | 0.636 * | ||
| 2 | E333 | OQ257172 | Alternaria sp. | HG936477 | 96 | 1 | 1 | 0.010 | ||||||||
| 3 | E332 | OQ257171 | Alternaria sp. | AF347031 | 94.8 | 1 | 1 | 0.010 | ||||||||
| 4 | E150 | OQ257077 | Epicoccum sp. | HQ630972 | 100 | 5 | 24 | 9 | 2 | 40 | 0.174 * | 0.245 * | 0.087 * | 0.182 | ||
| 5 | E137 | OQ257065 | Alternaria infectoria | MK461061 | 99.69 | 2 | 2 | 1 | 5 | 0.020 | 0.019 | 0.091 | ||||
| 6 | E149 | OQ257076 | Stemphylium vesicarium | MK461018 | 99.68 | 2 | 2 | 4 | 0.087 * | 0.020 | ||||||
| 7 | E302 | OQ257143 | Bipolaris sorokiniana | KU194490 | 100 | 3 | 3 | 0.031 | ||||||||
| 8 | E354 | OQ257187 | Periconia macrospinosa | JX981482 | 99.8 | 2 | 2 | 0.019 | ||||||||
| 9 | E358 | OQ257191 | Pithomyces chartarum | MH860227 | 100 | 1 | 1 | 0.010 | ||||||||
| 10 | E573 | OQ257304 | Neosetophoma italica | KP711356 | 99.84 | 1 | 1 | 0.043 | ||||||||
| 11 | E165 | OQ257091 | Parastagonospora nodorum | KX928830 | 98.89 | 1 | 1 | 0.010 | ||||||||
| 12 | E343 | OQ257177 | Periconia byssoides | KC954157 | 99.8 | 1 | 1 | 0.010 | ||||||||
| 13 | E307 | OQ257148 | Pyrenophora tritici-repentis | KT692571 | 99.6 | 1 | 1 | 0.010 | ||||||||
| 14 | E194 | OQ257100 | Neodidymelliopsis cannabis | MH859057 | 99.08 | 1 | 1 | 0.010 | ||||||||
| 50 | E546 | OQ257285 | Paraphoma sp. | DQ420980 | 91 | 1 | 1 | 0.043 | ||||||||
| 51 | E375 | OQ257207 | Sporormiella intermedia | JX136249 | 99.10 | 1 | 1 | 0.010 | ||||||||
| Dothideales | ||||||||||||||||
| 15 | E157 | OQ257083 | Aureobasidium pullulans | FN868454 | 100 | 1 | 7 | 2 | 10 | 0.043 | 0.071 | 0.019 | ||||
| Cladosporiales | ||||||||||||||||
| 16 | E159 | OQ257085 | Cladosporium sp. | HQ631003 | 100 | 11 | 12 | 1 | 24 | 0.112 * | 0.117 * | 0.091 | ||||
| Mycosphaerellales | ||||||||||||||||
| 17 | E559 | OQ257293 | Mycosphaerella sp. | EU167596 | 100 | 1 | 1 | 0.010 | ||||||||
| Botryosphaeriales | ||||||||||||||||
| 18 | E431 | OQ257234 | Diplodia sapinea | MF398866 | 98.1 | 1 | 1 | 0.010 | ||||||||
| SORDARIOMYCETES | ||||||||||||||||
| Diaporthales | ||||||||||||||||
| 19 | E374 | OQ257206 | Diaporthe novem | MH864504 | 100 | 1 | 1 | 3 | 5 | 10 | 0.037 | 0.043 | 0.031 | 0.049 * | ||
| 20 | E126 | OQ257055 | Diaporthe oncostoma | LN714541 | 99.83 | 1 | 4 | 5 | 0.043 | 0.041 * | ||||||
| 21 | E367 | OQ257200 | Diaporthe sp. | KJ482538 | 100 | 3 | 1 | 4 | 0. 031 | 0.010 | ||||||
| 22 | E321 | OQ257161 | Diaporthe foeniculina | AY620999 | 100 | 1 | 2 | 3 | 0.043 | 0.019 | ||||||
| 23 | E518 | OQ257262 | Diaporthe columnaris | MN450640 | 99.8 | 2 | 2 | 0.074 * | ||||||||
| 24 | E494 | OQ257241 | Cytospora sp. | AY618229 | 98.4 | 1 | 1 | 0.043 | ||||||||
| Glomerellales | ||||||||||||||||
| 25 | E365 | OQ257198 | Colletotrichum coccodes | AJ301984 | 99.50 | 1 | 2 | 3 | 0.010 | 0.019 | ||||||
| 26 | E346 | OQ257180 | Colletotrichum gloeosporioides | AJ301907 | 100 | 1 | 1 | 2 | 0.010 | 0.010 | ||||||
| 27 | E545 | OQ257284 | Plectosphaerella cucumerina | KF472138 | 98.8 | 2 | 2 | 0.074 * | ||||||||
| 28 | E432 | OQ257235 | Colletotrichum karsti | MW081181 | 99.19 | 1 | 1 | 0.010 | ||||||||
| 29 | E555 | OQ257291 | Colletotrichum acutatum | AJ301971 | 100 | 1 | 1 | 0.043 | ||||||||
| Hypocreales | ||||||||||||||||
| 30 | E569 | OQ257300 | Ilyonectria macrodidyma | JN859422 | 100 | 7 | 7 | 0.259 * | ||||||||
| 31 | E542 | OQ257282 | Fusarium sp. | MK408102 | 99.8 | 1 | 1 | 2 | 1 | 5 | 0.037 | 0.043 | 0.020 | 0.010 | ||
| 32 | E347 | OQ257181 | Fusarium sambucinum | KM231813 | 99.8 | 1 | 1 | 1 | 2 | 5 | 0.037 | 0.043 | 0.010 | 0.019 | ||
| 33 | E529 | OQ257272 | Fusarium oxysporum | MT453296 | 99.82 | 2 | 1 | 3 | 0.074 * | 0.010 | ||||||
| 34 | E523 | OQ257267 | Fusarium oxysporum | AY928418 | 100 | 2 | 2 | 0.074 * | ||||||||
| 35 | E519 | OQ257263 | Fusarium verticillioides | KJ957786 | 99.8 | 1 | 1 | 0.037 | ||||||||
| Xylariales | ||||||||||||||||
| 36 | E331 | OQ257170 | Nemania serpens | KU141386 | 100 | 1 | 1 | 0.010 | ||||||||
| 37 | E521 | OQ257265 | Truncatella angustata | MT514368 | 99.6 | 1 | 1 | 0.037 | ||||||||
| 38 | E425 | OQ257228 | Nigrospora sphaerica | HQ608063 | 100 | 1 | 1 | 0.010 | ||||||||
| LEOTIOMYCETES | ||||||||||||||||
| Helotiales | ||||||||||||||||
| 39 | E235 | OQ257130 | Botrytis cinerea | MH860108 | 100 | 8 | 8 | 0.078 * | ||||||||
| EUROTIOMYCETES | ||||||||||||||||
| Eurotiales | ||||||||||||||||
| 40 | E554 | OQ257290 | Penicillium sp. | KF367497 | 100 | 3 | 3 | 0.111 * | ||||||||
| 41 | E490 | OQ257238 | Penicillium sp. | MN861278 | 98.04 | 1 | 1 | 0.037 | ||||||||
| 42 | E161 | OQ257087 | Aspergillus sp. | MK461022 | 99 | 1 | 1 | 0.010 | ||||||||
| 43 | E536 | OQ257278 | Talaromyces wortmannii | NR_172039 | 99.8 | 1 | 1 | 0.037 | ||||||||
| BASIDIOMYCOTA | ||||||||||||||||
| AGARICOMYCETES | ||||||||||||||||
| Polyporales | ||||||||||||||||
| 44 | E148 | OQ257075 | Hyphodermella rosae | MF475983 | 99.84 | 1 | 1 | 0.010 | ||||||||
| Cantharellales | ||||||||||||||||
| 45 | E544 | OQ257283 | Rhizoctonia solani | MH862557 | 99.69 | 1 | 1 | 0.037 | ||||||||
| TREMELLOMYCETES | ||||||||||||||||
| Cystofilobasidiales | ||||||||||||||||
| 46 | E557 | OQ257292 | Itersonilia perplexans | MH861890 | 99.69 | 1 | 1 | 0.010 | ||||||||
| Tremellales | ||||||||||||||||
| 47 | E142 | OQ257070 | Vishniacozyma heimaeyensis | KY105824 | 100 | 1 | 1 | 0.010 | ||||||||
| 48 | E143 | OQ257071 | Cryptococcus sp. | EU852359 | 99.8 | 1 | 1 | 0.010 | ||||||||
| MUCOROMYCOTA | ||||||||||||||||
| MUCOROMYCETES | ||||||||||||||||
| Mucorales | ||||||||||||||||
| 49 | E520 | OQ257264 | Mucor fragilis | GU566275 | 99.8 | 1 | 1 | 0.037 | ||||||||
| Total no. isolates | 27 | 24 | 98 | 102 | 11 | 262 | ||||||||||
| Species richness | 14 | 13 | 25 | 20 | 4 | 51 | ||||||||||
| 1/S | 0.067 | 0.077 | 0.040 | 0.045 | 0.250 | |||||||||||
| OTU No. | Taxon | Sampling Sites | |||||||||
|---|---|---|---|---|---|---|---|---|---|---|---|
| P | V | C | B | N | P | Bo | O | Ps | Pr | ||
| 1 | Alternaria sp. | 6 | 7 | 17 | 15 | 7 | 10 | 12 | 4 | 4 | |
| 2 | Alternaria sp. | 1 | |||||||||
| 3 | Alternaria sp. | 1 | |||||||||
| 4 | Epicoccum sp. | 9 | 3 | 13 | 4 | 3 | 8 | ||||
| 5 | Alternaria infectoria | 1 | 2 | 1 | 1 | ||||||
| 6 | Stemphylium vesicarium | 2 | 2 | ||||||||
| 7 | Bipolaris sorokiniana | 2 | 1 | ||||||||
| 8 | Periconia macrospinosa | 2 | |||||||||
| 9 | Pithomyces chartarum | 1 | |||||||||
| 10 | Neosetophoma italica | 1 | |||||||||
| 11 | Parastagonospora nodorum | 1 | |||||||||
| 12 | Periconia byssoides | 1 | |||||||||
| 13 | Pyrenophora tritici-repentis | 1 | |||||||||
| 14 | Neodidymelliopsis cannabis | 1 | |||||||||
| 39 | Botrytis cinerea | 2 | 5 | 1 | |||||||
| 15 | Aureobasidium pullulans | 1 | 2 | 2 | 5 | ||||||
| 16 | Cladosporium sp. | 4 | 2 | 7 | 2 | 4 | 1 | 3 | 1 | ||
| 17 | Mycosphaerella sp. | 1 | |||||||||
| 18 | Diplodia sapinea | 1 | |||||||||
| 19 | Diaporthe novem | 2 | 4 | 1 | 2 | 1 | |||||
| 20 | Diaporthe oncostoma | 3 | 2 | ||||||||
| 21 | Diaporthe sp. | 1 | 2 | 1 | |||||||
| 22 | Diaporthe foeniculina | 1 | 2 | ||||||||
| 23 | Diaporthe columnaris | 1 | 1 | ||||||||
| 24 | Cytospora sp. | 1 | |||||||||
| 25 | Colletotrichum coccodes | 1 | 1 | 1 | |||||||
| 26 | Colletotrichum gloeosporioides | 1 | 1 | ||||||||
| 27 | Plectosphaerella cucumerina | 2 | |||||||||
| 28 | Colletotrichum karsti | 1 | |||||||||
| 29 | Colletotrichum acutatum | 1 | |||||||||
| 30 | Ilyonectria macrodidyma | 4 | 3 | ||||||||
| 31 | Fusarium sp. | 1 | 2 | 2 | |||||||
| 32 | Fusarium sambucinum | 3 | 2 | ||||||||
| 33 | Fusarium oxysporum | 1 | 2 | ||||||||
| 34 | Fusarium oxysporum | 1 | 1 | ||||||||
| 35 | Fusarium verticillioides | 1 | |||||||||
| 36 | Nemania serpens | 1 | |||||||||
| 37 | Truncatella angustata | 1 | |||||||||
| 38 | Nigrospora sphaerica | 1 | |||||||||
| 40 | Penicillium sp. | 3 | |||||||||
| 41 | Penicillium sp. | 1 | |||||||||
| 42 | Aspergillus sp. | 1 | |||||||||
| 43 | Talaromyces wortmannii | 1 | |||||||||
| 44 | Hyphodermella rosae | 1 | |||||||||
| 45 | Rhizoctonia solani | 1 | |||||||||
| 46 | Itersonilia perplexans | 1 | |||||||||
| 47 | Vishniacozyma heimaeyensis | 1 | |||||||||
| 48 | Cryptococcus sp. | 1 | |||||||||
| 49 | Mucor fragilis | 1 | |||||||||
| 50 | Paraphoma sp. | 1 | |||||||||
| 51 | Sporormiella intermedia | 1 | |||||||||
| Total no. isolates | 31 | 23 | 62 | 34 | 23 | 51 | 14 | 5 | 14 | 5 | |
| Species richness | 11 | 10 | 18 | 15 | 8 | 20 | 3 | 4 | 8 | 2 | |
| Isolate Name | PATHOGENIC FUNGUS | |||
|---|---|---|---|---|
| E140_OTU1_Alternaria sp. | E529_OTU33_F. oxysporum | AR593_B. cinerea | AR397s2_S. sclerotiorum | |
| ENDOPHYTIC FUNGUS | ||||
| E150_OTU4_Epicoccum sp. | −/15.3 | −/0 | +/0 | +/0 |
| E157_OTU15_Aureobasidium pullulans | −/0 | −/0 | +/27.3 | −/12.5 |
| E545_OTU27_Plectosphaerella cucumerina | +/40.9 | −/0 | −/0 | −/0 |
| E149_OTU6_Stemphylium vesicarium | +/7.5 | −/12.0 | −/0 | −/10.9 |
| E343_OTU12_Periconia byssoides | +/0 | −/6.5 | −/0 | +/8.97 |
| E536_ OTU43_Talaromyces wortmannii | −/0 | +/5.6 | −/0 | −/8.97 |
| E425_OTU38_Nigrospora sphaerica | +/15.6 | −/3.2 | −/0 | +/14.5 |
Disclaimer/Publisher’s Note: The statements, opinions and data contained in all publications are solely those of the individual author(s) and contributor(s) and not of MDPI and/or the editor(s). MDPI and/or the editor(s) disclaim responsibility for any injury to people or property resulting from any ideas, methods, instructions or products referred to in the content. |
© 2025 by the authors. Licensee MDPI, Basel, Switzerland. This article is an open access article distributed under the terms and conditions of the Creative Commons Attribution (CC BY) license (https://creativecommons.org/licenses/by/4.0/).
Share and Cite
Riccioni, C.; Belfiori, B.; Cenci, M.; Rubini, A. Exploring Endophytic Fungi from Humulus lupulus L. for Biocontrol of Phytopathogenic Fungi. Diversity 2025, 17, 94. https://doi.org/10.3390/d17020094
Riccioni C, Belfiori B, Cenci M, Rubini A. Exploring Endophytic Fungi from Humulus lupulus L. for Biocontrol of Phytopathogenic Fungi. Diversity. 2025; 17(2):94. https://doi.org/10.3390/d17020094
Chicago/Turabian StyleRiccioni, Claudia, Beatrice Belfiori, Maurizio Cenci, and Andrea Rubini. 2025. "Exploring Endophytic Fungi from Humulus lupulus L. for Biocontrol of Phytopathogenic Fungi" Diversity 17, no. 2: 94. https://doi.org/10.3390/d17020094
APA StyleRiccioni, C., Belfiori, B., Cenci, M., & Rubini, A. (2025). Exploring Endophytic Fungi from Humulus lupulus L. for Biocontrol of Phytopathogenic Fungi. Diversity, 17(2), 94. https://doi.org/10.3390/d17020094

